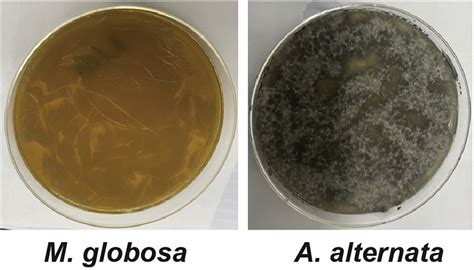
Ilustrácia mikroskopického pohľadu na Malassezia globosa

Lupiny sú bežným problémom, ktorý postihuje veľkú časť populácie a môžu sa objaviť nielen na pokožke hlavy, ale aj na iných častiach tela, vrátane brady a obočia. Tento stav, hoci často neškodný, môže byť esteticky nepríjemný a spôsobovať svrbenie a podráždenie. Pochopenie príčin a správna liečba sú kľúčové pre zvládnutie tohto problému.
Čo sú to lupiny?
Lupiny sú stav, pri ktorom sa odumreté kožné bunky odlupujú z pokožky hlavy alebo iných častí tela. Ide o chronické ochorenie pokožky, ktoré môže postihnúť milióny ľudí na celom svete. Tento stav je často spojený so svrbením, začervenaním a tvorbou bielych alebo žltých šupiniek.
Lupiny môžu byť spôsobené kombináciou viacerých faktorov. Medzi hlavné príčiny patria:
- Mikróby: Prirodzene sa vyskytujúci mikrób Malassezia globosa sa nachádza na pokožke hlavy každého človeka. Živí sa prirodzeným mazom (sébum) na pokožke hlavy. Keď sa rovnováha vylučovania mazu naruší, vytvára sa vedľajší produkt, nazývaný kyselina olejová. Odhaduje sa, že päťdesiat percent ľudí je citlivých na kyselinu olejovú, preto ich pokožka hlavy reaguje podráždením a zápalom.
- Citlivá pokožka hlavy: Niektorí ľudia majú citlivejšiu pokožku, ktorá reaguje na kyselinu olejovú podráždením a zápalom.
- Mastná pokožka: Nadmerná produkcia kožného mazu (seborea) môže viesť k tvorbe lupín. Seborea môže byť spôsobená hormonálnymi zmenami, stresom alebo genetickou predispozíciou.
- Suchá pokožka: Naopak, extrémne suchá pokožka, najmä v chladnejšom prostredí alebo v zime, môže tiež viesť k tvorbe drobných, bielych šupiniek.
- Nedostatočná alebo nadmerná hygiena: Nedostatočné umývanie vlasov môže spôsobiť nahromadenie mazu a odumretých kožných buniek. Príliš časté umývanie vlasov však môže pokožku hlavy vysušovať.
- Reakcia na vlasové produkty: Niektoré šampóny, stylingové produkty alebo iné vlasové prípravky môžu spôsobiť podráždenie alebo alergickú reakciu, ktorá vedie k tvorbe lupín.
- Znečistenie vzduchu: Chemikálie vo vzduchu môžu ovplyvniť pokožku a spôsobiť podráždenie alebo alergické reakcie.
- Nevyvážená strava: Nedostatok určitých živín, ako sú vitamíny skupiny B, zinok a omega-3 mastné kyseliny, môže prispieť k tvorbe lupín.
- Stres: Stres môže oslabiť imunitný systém a zhoršiť stav pokožky, čo môže viesť k premnoženiu kvasiniek a tvorbe lupín.
Lupiny na brade a obočí
Lupiny sa môžu objaviť aj na brade a obočí. V týchto prípadoch príčiny bývajú podobné ako pri lupinách na pokožke hlavy. Ide najmä o seboroickú dermatitídu, ktorá postihuje oblasti s vyššou koncentráciou mazových žliaz, vrátane tváre. Pri seboroickej dermatitíde sa môžu objaviť mastné, žltkasté šupinky, začervenanie a svrbenie. V prípade suchej pokožky môžu byť šupinky menšie a bledšie.
Príznaky lupín na brade a obočí
Hlavné príznaky lupín na brade a obočí zahŕňajú:
- Tvorba bielych, sivých alebo žltkastých šupiniek.
- Svrbenie a podráždenie pokožky.
- Začervenanie postihnutej oblasti.
- Suchá, drsná alebo šupinatá pokožka.
Je dôležité odlíšiť lupiny od iných kožných problémov, ako je napríklad ekzém, psoriáza alebo kontaktná dermatitída. V prípade nejasností je vhodné poradiť sa s lekárom.

Liečba lupín na brade a obočí
Liečba lupín závisí od ich príčiny. V mnohých prípadoch môžu pomôcť bežné domáce prostriedky a zmeny v starostlivosti:
- Šampóny proti lupinám: Používanie šampónov proti lupinám, ktoré obsahujú aktívne zložky ako ketokonazol, pyrithion zinočnatý alebo kyselinu salicylovú, môže byť účinné. Tieto šampóny by sa mali používať na postihnuté oblasti podľa návodu.
- Správna hygiena: Pravidelné umývanie tváre a brady jemnými čistiacimi prostriedkami je dôležité. Vyhnite sa drsnému drhnutiu pokožky.
- Hydratácia: Používanie hydratačných krémov alebo olejov môže pomôcť zmierniť suchosť a svrbenie. Vhodné sú prírodné oleje ako tea tree olej, olivový olej alebo kokosový olej, ktoré majú aj antimikrobiálne vlastnosti.
- Vyvážená strava: Strava bohatá na zinok, vitamíny skupiny B a omega-3 mastné kyseliny môže podporiť zdravie pokožky.
- Redukcia stresu: Relaxačné techniky, dostatočný spánok a vyhýbanie sa stresovým situáciám môžu pomôcť zlepšiť stav pokožky.
- Vyhnite sa dráždivým produktom: Ak používate špecifické produkty na bradu alebo obočie, uistite sa, že nie sú príliš drsné alebo alergénne.
V prípade pretrvávajúcich alebo závažných príznakov je dôležité navštíviť lekára alebo dermatológa, ktorý môže predpísať silnejšie lieky, ako sú antimykotické krémy alebo kortikosteroidy.
Burn This for 1 Minute and Watch the Insects Disappear!
Čo robiť, ak máte alergiu na šampóny proti lupinám?
Ak máte alergiu na zložky bežných šampónov proti lupinám, môžete vyskúšať prírodné alternatívy. Esenciálne oleje ako tea tree, santalový, šalviový, bergamotový, levanduľový, patchuli, rozmarínový, petit grain alebo cédrový olej môžu pomôcť vďaka svojim antimikrobiálnym a protizápalovým vlastnostiam. Môžete ich pridať do jemného šampónu alebo použiť priamo na postihnuté miesta.
Prevencia lupín
Prevencia lupín zahŕňa udržiavanie zdravej pokožky, správnu hygienu a zdravý životný štýl. Pravidelné umývanie, dostatočná hydratácia, vyvážená strava a zvládanie stresu môžu pomôcť predchádzať vzniku lupín na brade aj obočí.

Je dôležité pamätať na to, že lupiny sú často chronickým stavom, ktorý si vyžaduje dlhodobú starostlivosť a trpezlivosť. Správnou starostlivosťou a v prípade potreby aj lekárskou pomocou je však možné dosiahnuť výrazné zlepšenie.